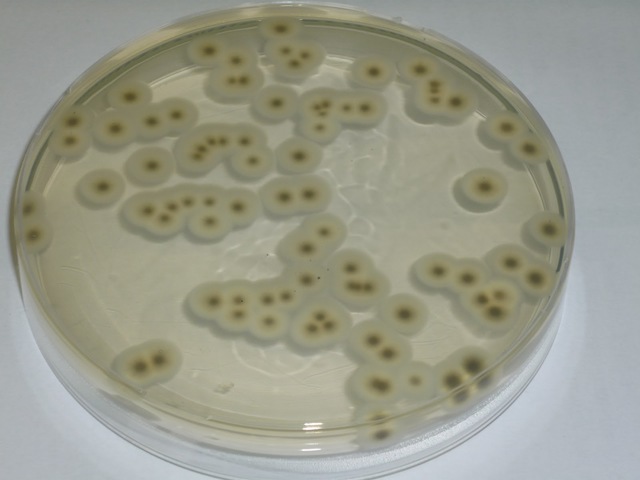
Richard Petri

-
(1590-1608) desarrolla el primer microscopio compuesto.Zacharias Janssen hijo de Hans Janssen, nació en Middelburg, en los Países Bajos, en 1588 y murió en esa misma ciudad en 1638.1 Provenía de una familia que fabricaba lentes. Su padre fue Hans Janssen. Aunque el origen del microscopio es una cuestión aún incierta
, se le considera como el inventor del microscopio compuesto (con dos lentes), tal vez con la ayuda de su padre, en el año 1595. -
fue el primero en refutar la teoría de la generación espontánea en gusanos.
planteó un experimento sencillo pero contundente para refutar las creencias acerca de la aparición súbita y espontánea de los seres vivos. La preocupación de Redi era investigar el origen de los gusanos que aparecían en la carne en descomposición. Para dilucidar si era cierta la noción de que los gusanos surgían por generación espontánea o si estos organismos tenían otro origen.
Redi llevó a cabo un experimento en el qu -
Es el primero en observar bacterias o "animálculos".
El descubrimiento de los protozoarios[editar]
Fue probablemente la primera persona en observar bacterias y otros microorganismos. En una carta fechada el 7 de septiembre de 1674, evoca por primera vez las minúsculas formas de vida que observó en las aguas de un lago cerca de Delft. Después de haber mencionado de nuevo estas criaturas en dos cartas, una del 20 de diciembre de 1675 y otra del 22 de enero de 1676, en una extensa carta de diecisie -
Desarrolla la primera vacuna contra la viruela humana. tuvo la idea de inocular a una persona sana con la viruela de las vacas para conferirle inmunidad frente a la terrible enfermedad.El 14 de mayo de 1796 extrajo pus de una pústula de la mano de Sarah Nelmes, una ordeñadora que había contraído la viruela de su vaca lechera, y lo inoculó a un saludable niño de 8 años desarrollo una leve enfermedad entre el 7º y el 9º día. Se formó una vesícula en los puntos de inoculación, que desaparecio.
-
demuestra que una enfermedad del gusano de seda era producida por un hongo.
Hizo un gran descubrimiento en la bacteriología moderna. La primera prueba experimental de un agente biológico como causa de una enfermedad epidémica la proporcionó Agostino Bassi en 1835, que pudo demostrar que cierta enfermedad del gusano de seda, que había hecho su aparición en Lombardía, se debía al hongo Botrytis bassiana. -
descubre un hongo (Phytophthora infestans) que produce la podredumbre de la patata.
-
propone la utilización de antisépticos para evitar la fiebre puerperal. fue un médico húngaro de origen alemán que consiguió disminuir drásticamente la tasa de mortalidad en un 70 % por sepsis puerperal (una forma de fiebre puerperal)
-
Realiza el primer estudio epidemiológico del cólera en Londres.
-
algodon para cerrar las trompas y los frascos para evitar contaminacion microbiana en los caldos de cultivo con calefaccion.
-
descubre el DNA (ácido nucleico) en el esperma de trucha.
comenzó sus investigaciones con el esperma de los salmones, y descubrió la presencia de una serie de sustancias, una ácida (ácido nucléico o "nucleína") y una fuertemente básica, a la que denominó "protamina" y que se identifica con las histonas.Los estudios de Miescher tuvieron un papel muy importante en la biología molecular, que abrió las puertas a numerosas pruebas y experimentos el término nucleína y él nunca lo propuso como el ADN. -
Refuta de manera convincente la teoría de la generación espontánea.
-
observa que la fiebre amarilla es transmitida por mosquitos.
-
descubre el Mycobacterium tuberculosis.
-
es un tipo de tinción diferencial empleado en bacteriología para la visualización de bacterias, sobre todo en muestras clínicas. Debe su nombre al bacteriólogo danés Christian Gram (1853-1938), que desarrolló la técnica en 1884. Se utiliza tanto para poder referirse a la morfología celular bacteriana, como para poder realizar una primera aproximación a la diferenciación bacteriana, considerándose bacterias gram positivas a las que se visualizan de color morado, y bacterias gram (-) color rosa.
-
puso a punto una vacuna contra la rabia.
-
descubre Escherichia coli.
-
introduce el uso de las placas Petri en Microbiología
-
aísla bacterias fijadoras de nitrógeno de los nódulos presentes en las raíces de leguminosas.
-
estudia las bacterias del azufre y las bacterias nitrificantes.
-
Demuestra que el mosaico del tabaco es producido por un virus.
-
Demuestran que la bacteria Yersinia pestis era el microorganismo causante de la peste.
-
demuestran que el Treponema pálidum es el agente productor de la sífilis.
-
demuestra que la fiebre de las Montañas Rocosas es transmitida por garrapatas, y aisló el microorganismo causante de la enfermedad (que él llamó rickettsia). Falleció por esa enfermedad.
-
descubre el salvarsán (balas mágicas), primer agente quimioterapéutico contra la sífilis.
-
Rous descubre el virus (retrovirus) que produce tumores (sarcomas) en pollos
-
descubre los virus que infectan bacterias (bacteriófagos)
-
lleva a cabo el descubrimiento de la transformación bacteriana.
-
- aísla la penicilina de un cultivo de Penicillium notatum.
-
Frits Zernike desarrolla el microscopio de contraste de fases que permite ver microorganismos vivos.
- Helmut Ruska inventa el microscopio electrónico. -
descubre las sulfamidas, el primer agente quimioterapeútico.
-
Stanley consigue cristalizar el virus del mosaico del tabaco (que permaneció activo después de la cristalización)
-
demuestran que el DNA es el material genético
-
descubren el fenómeno de la transducción generalizada.
-
introduce el concepto de plásmido.Los plásmidos son moléculas de ADN extracromosómico circular o lineal que se replican y transcriben independientes del ADN cromosómico. Están presentes normalmente en bacterias, y en algunas ocasiones en organismos eucariotas como las levaduras. Su tamaño varía desde 3 a 10 kb. El número de plásmidos puede variar, dependiendo de su tipo, desde una sola copia hasta algunos cientos por célula.
-
proporcionan el primer ejemplo de control de la expresión de genes a nivel de transcripción: modelo del operón.
-
descubren que el codón UUU codificaba para el aminoácido fenilalanina, experimento que sentó las bases para la elucidación del código genético.
-
aísla los tRNA, moléculas que incorporan los aminoácidos activados en las proteínas.
-
descubren los enzimas de restricción, herramientas esenciales para el desarrollo de la Ingeniería Genética.
-
pone a punto un test bacteriano para detectar mutágenos y carcinógenos: el test de Ames.
-
reconocen las archeas como el tercer dominio de los seres vivos
-
se produce insulina humana usando bacterias Escherichia coli mediante técnicas de ingeniería genética. Se comercializó en 1982.
-
llevan a cabo el aislamiento e identificación del virus del sida.
-
descubren Epulopiscium fishelsoni, la mayor célula procariota
-
se secuencia el genoma del hongo Saccharomyces cerevisiae.
-
es una proteobacteria gram-negativa encontrada en los sedimentos oceánicos de la plataforma continental. Es la mayor bacteria conocida, con una longitud de hasta 750 μm (0,75 mm),[1] lo que la hace visible a simple vista.
-
aparece en China la neumonía atípica (síndrome respiratorio agudo, SARS), enfermedad respiratoria producida por un coronavirus.
-
aparece en Asia la gripe aviar, producida por el subtipo H5N1 del virus Influenza A que puede transmitirse al hombre.
-
Secuenciación del genoma de Legionella pneumophila, el microorganismo productor de la enfermedad de los legionarios,Es una infección de los pulmones y las vías respiratorias causada por la bacteria Legionela:agrupa bacterias Gram negativas con forma de bacilo. Viven en aguas estancadas con un amplio rango de temperatura, preferiblemente superior a 35ºC.
-
se secuencia el genoma del Saccharopolyspora erythraea, el microorganismo productor del antibiótico eritromicina.
-
en México aparece un brote de gripe porcina, posteriormente llamada gripe A H1N1
-
puede producir dos esporas en la misma célula madre,es una bacteria Gram positiva, Catalasa-positiva, aerobio comúnmente encontrada en el suelo. Miembro del Género Bacillus, B. subtilis tiene la habilidad para formar una resistente endospora protectora, permitendo al organismo tolerar condiciones ambientalmente extremas.
-
Mycobacterium es el único género de la familia de las bacterias Mycobacteriaceae. Por las características únicas entre otros géneros bacterianos y por la importancia médica de las mismas, se estudian en la sub-rama de la Microbiología llamada micobacteriologia.
Mycobacterium está formado por bacilos aeróbios inmóviles y no esporulados con un tamaño de 0,2 a 0,6 x 1 a 10 µm1 algunos de los cuáles son patógenos que causan graves enfermedades en los mamíferos, incluyendo tuberculosis y la lepra. -
se secuencia el genoma de la bacteria Haemophilus influenzae.